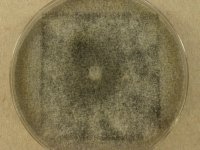

<< back to search
IMAGES:


Search Details
add to cart
| UAMH Number: | 11357 |
|---|---|
| Species Name: | Grosmannia clavigera |
| Type: | |
| Synonyms: | Ceratocystis clavigera / Europhium clavigerum / Ophiostoma clavigerum |
| Taxonomy: | FUNGI Ascomycota, Sordariomycetes, Ophiostomatales, Ophiostomataceae |
| Strain History: | D. Six (HV30) -> Breuil, C. (HV30) -> UAMH |
| Substrate: | mountain pine beetle (Dendroctonus ponderosae) in Pinus contorta | Location: | USA Montana, Hidden Valley (GEO: 46.987,-104.19) |
| Isolator: | D. Six (HV30) |
| Isolation Date: | 2003 |
| Date Received: | 2011-01-10 |
| Characters: | |
| Compounds: | |
| Cross Reference: | |
| Pathogenic Potential: | Human: no | Animal: no | Plant: yes |
| Biosafety Risk Group: | RG1 (check the PHAC ePATHogen Risk Group Database for updates) |
| Regulatory Requirements: | Canadian requesters must provide a CFIA Written Authorization for transfer (http://www.inspection.gc.ca/plants/plant-pests-invasive-species/directives/date/d-12-03/eng/1432656209220/1432751554580#app2) prior to shipment. International requesters must provide all legally required importation documentation prior to shipment. This strain is not available for shipment to Cuba, the Democratic People's Republic of Korea, Iran or Syria. Plant pathogenicity status may be verified by using the USDA Agricultural Research Service (ARS) Fungal Database |
| MycoBank ID: | 500813 |
IMAGES: